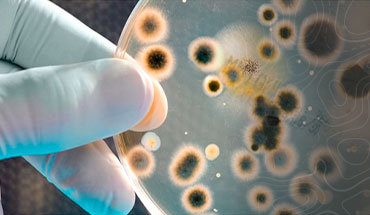
Image

GOODBYE MOLD
Goodbye Mold is an environmental fully licensed, insured, and certified mold expert company, specializing in identifying the sources of mold and mildew, testing and remediation at residential and commercial properties in South Florida
Our mission is providing you the highest level of indoor air quality, staying free of mycotoxins and the most comfortable atmosphere you deserve, without health risks. Since foundation, Goodbye mold has been providing services with experience, performance, customer focus, integrity and teamwork.
SERVICES
Mold inspection
We develop and understand project expectations and then manage those needs with a design team.
Mold testing and samples with lab results
We work closely with architects to understand the project, and ultimately develop a targeted.

Mold removal
In the past decade alone, we have completed more than 5 million square feet of metal building.

Mold remediation
In the past decade alone, we have completed more than 5 million square feet of metal building.












